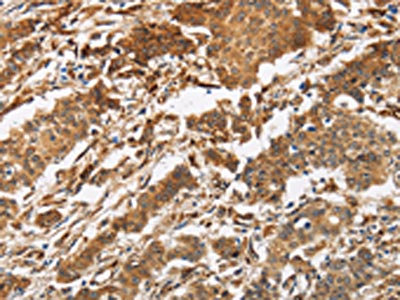

CALU Antibody
-
中文名稱(chēng):CALU兔多克隆抗體
-
貨號(hào):CSB-PA984693
-
規(guī)格:¥1100
-
圖片:
-
The image is immunohistochemistry of paraffin-embedded Human gastic cancer tissue using CSB-PA984693(CALU Antibody) at dilution 1/40. (Original magnification: ×200)
-
The image is immunohistochemistry of paraffin-embedded Human liver cancer tissue using CSB-PA984693(CALU Antibody) at dilution 1/40. (Original magnification: ×200)
-
-
其他:
產(chǎn)品詳情
-
Uniprot No.:
-
基因名:CALU
-
別名:CALU antibody; CALU_HUMAN antibody; Calumenin 1 antibody; Calumenin 2 antibody; Calumenin antibody; Crocalbin antibody; crocalbin-like protein antibody; FLJ90608 antibody; IEF SSP 9302 antibody; multiple EF-hand protein antibody; OTTHUMP00000212712 antibody; OTTHUMP00000212713 antibody; OTTHUMP00000212714 antibody; OTTHUMP00000212715 antibody
-
宿主:Rabbit
-
反應(yīng)種屬:Human,Mouse,Rat
-
免疫原:Fusion protein of Human CALU
-
免疫原種屬:Homo sapiens (Human)
-
標(biāo)記方式:Non-conjugated
-
抗體亞型:IgG
-
純化方式:Antigen affinity purification
-
濃度:It differs from different batches. Please contact us to confirm it.
-
保存緩沖液:-20°C, pH7.4 PBS, 0.05% NaN3, 40% Glycerol
-
產(chǎn)品提供形式:Liquid
-
應(yīng)用范圍:ELISA,IHC
-
推薦稀釋比:
Application Recommended Dilution ELISA 1:2000-1:10000 IHC 1:100-1:300 -
Protocols:
-
儲(chǔ)存條件:Upon receipt, store at -20°C or -80°C. Avoid repeated freeze.
-
貨期:Basically, we can dispatch the products out in 1-3 working days after receiving your orders. Delivery time maybe differs from different purchasing way or location, please kindly consult your local distributors for specific delivery time.
-
用途:For Research Use Only. Not for use in diagnostic or therapeutic procedures.
相關(guān)產(chǎn)品
靶點(diǎn)詳情
-
功能:Involved in regulation of vitamin K-dependent carboxylation of multiple N-terminal glutamate residues. Seems to inhibit gamma-carboxylase GGCX. Binds 7 calcium ions with a low affinity.
-
基因功能參考文獻(xiàn):
- Replacing Leu with Gly (L150G) in Calu1 enables the protein to adopt a structural fold even in the Ca(2+) free form. The fourth (of seven) EF-hand of HsCalu1 nucleates the structural fold of the protein depending on the switch residue (Gly or Leu). PMID: 29319298
- The Calumenin modulates Sarco/Endoplasmic reticulumCa2+ATPase (SERCA) pump activity without drastically affecting ER-Ca(2+) concentration. PMID: 28189267
- Calu-15, a novel isoform of Calu with phosphorylation-dependent nuclear localization, has a critical role in promoting filopodia formation and cell migration by upregulating the GDF-15 transcription. PMID: 24136234
- Results provide direct evidence for the involvement of CALU and LGALS3BP as potential negative regulators in the virus-triggered induction of the typeI interferons. PMID: 26124285
- Results show that OSBPL5 and CALU were expressed at higher levels in the lung tissues of metastasis-positive cases than that in the metastasis-negative cases suggesting they can promote invasiveness of lung cancer cells. PMID: 25963840
- CALU polymorphism A29809G affects calumenin availability involving vascular calcification PMID: 25823396
- Calumenin is characterized as a charged protein exhibiting close similarity with intrinsically disordered proteins and is hypothesized to regulate F508del-CFTR folding by electrostatic effects. PMID: 25120007
- Calumenin is a new CFTR chaperone. PMID: 22768251
- Study found the secretion of calu-1/2-EGFP required microtubule integrity, and that calu-1/2-EGFP-containing vesicles were transported by the motor proteins Kif5b and cytoplasmic dynein. PMID: 22514732
- Quantitative PCR assays for VKORC1, CYP4F2, GGCX and CALU identified two copies in all populations. PMID: 22188360
- associated with arterial calcification and short-term prognosis of the outcome of patients with non-ST-elevation acute coronary syndrome PMID: 20673165
- Data show that calumenin in the presence of calcium binds specifically to thrombospondin-1, but closely-related reticulocalbin does not form a similar complex. PMID: 18688696
顯示更多
收起更多
-
亞細(xì)胞定位:Endoplasmic reticulum membrane. Golgi apparatus. Secreted. Melanosome. Sarcoplasmic reticulum lumen.
-
蛋白家族:CREC family
-
組織特異性:Ubiquitously expressed. Expressed at high levels in heart, placenta and skeletal muscle, at lower levels in lung, kidney and pancreas and at very low levels in brain and liver.
-
數(shù)據(jù)庫(kù)鏈接:
Most popular with customers
-
-
YWHAB Recombinant Monoclonal Antibody
Applications: ELISA, WB, IHC, IF, FC
Species Reactivity: Human, Mouse, Rat
-
Phospho-YAP1 (S127) Recombinant Monoclonal Antibody
Applications: ELISA, WB, IHC
Species Reactivity: Human
-
-
-
-
-